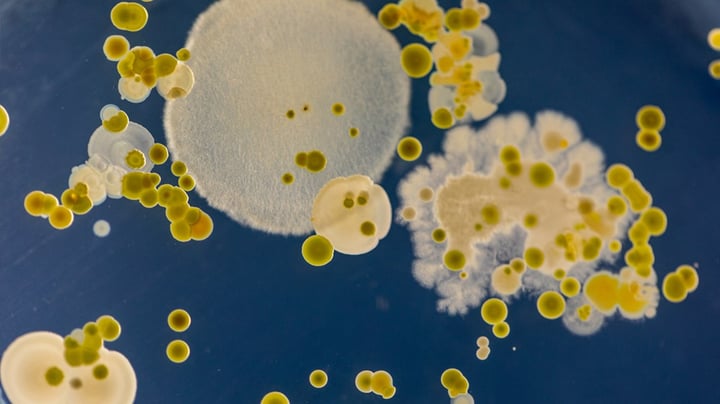
GMO har fået navneforandring. Nu hedder det NGT

Bioøkonomi
Læs mindre – forstå mere
Køb abonnement på Mandag Morgen og bliv klogere på de vigtigste dagsordner
Allerede abonnent? Log ind
Vi har fokus på det, der ændrer samfundet
Gå direkte til et af Mandag Morgens 4 fokusområder
Nyt fra Mandag Morgen
Få overblikket direkte i din mail
Tilmeld dig nyhedsbrevet her
- ChefredaktørAndreas Baumann
- Adm DirektørAnne Marie Kindberg
- CFOAnders Jørning
- Ansv. ChefredaktørJakob Nielsen
- Kommerciel direktørMichael Thomsen
- Formand og udgiverRasmus Nielsen
AdresseNy Kongensgade 101472 København KTlf. 33 93 93 23mm@mm.dkCVR nr.: 38253395
Mandag Morgen leveres af Mandag Morgen ApS, der ejes af Alrow Media ApS.